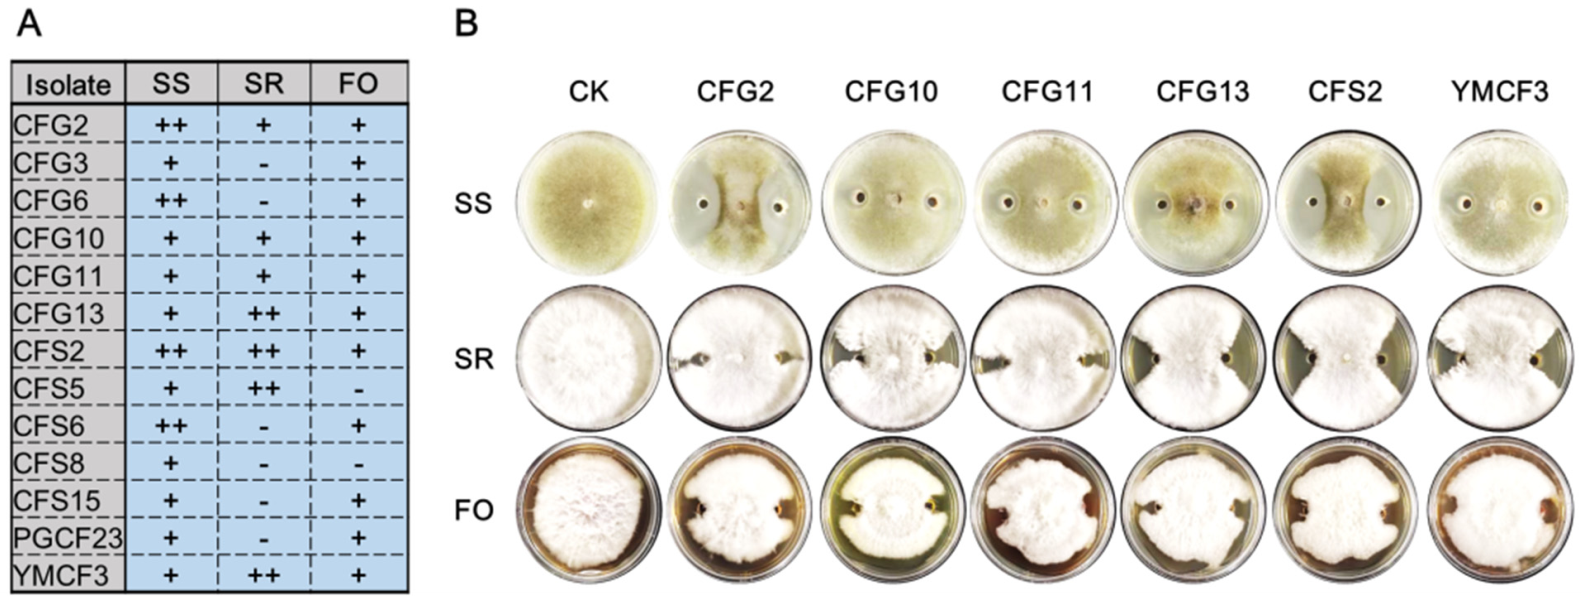
Microorganisms 10 00311 g004 550

Characterization of Microorganisms from Protaetia brevitarsis Larva Frass
Abstract
:1. Introduction
2. Materials and Methods
2.1. Insects, Rearing Conditions and Sampling
2.2. Bacillus Isolation from PBL Frass
2.3. High-Throughput Sequencing (HTS) and Bioinformatic Analyses
2.4. Bioassay
3. Results
3.1. Microbial Diversity Comparisons between Samples
3.2. Bacillus Isolation and Genome Analysis
3.3. Bacillus Is a Key Factor for Disease Resistance and Plant Growth Promotion
4. Discussion
Author Contributions
Funding
Institutional Review Board Statement
Informed Consent Statement
Data Availability Statement
Acknowledgments
Conflicts of Interest
References
- Wang, K.; Li, P.; Gao, Y.; Liu, C.; Wang, Q.; Yin, J.; Zhang, J.; Geng, L.; Shu, C. De novo genome assembly of the white-spotted flower chafer (Protaetia brevitarsis). Gigascience 2019, 8, giz019. [Google Scholar] [CrossRef] [PubMed] [Green Version]
- Li, Y.; Fu, T.; Geng, L.; Shi, Y.; Chu, H.; Liu, F.; Liu, C.; Song, F.; Zhang, J.; Shu, C. Protaetia brevitarsis larvae can efficiently convert herbaceous and ligneous plant residues to humic acids. Waste Manag. 2019, 83, 79–82. [Google Scholar] [CrossRef] [PubMed]
- Wei, P.; Li, Y.; Lai, D.; Geng, L.; Liu, C.; Zhang, J.; Shu, C.; Liu, R. Protaetia brevitarsis larvae can feed on and convert spent mushroom substrate from Auricularia auricula and Lentinula edodes cultivation. Waste Manag. 2020, 114, 234–239. [Google Scholar] [CrossRef] [PubMed]
- Zhang, X.; Wang, L.; Liu, C.; Liu, Y.; Mei, X.; Wang, Z.; Zhang, T. Identification and field verification of an aggregation pheromone from the white-spotted flower chafer, Protaetia brevitarsis Lewis (Coleoptera: Scarabaeidae). Sci. Rep. 2021, 11, 22362. [Google Scholar] [CrossRef] [PubMed]
- Seo, Y.S.; Shin, N.; Nam, H.H.; Song, J.; Moon, B.C.; Choi, G.; Shin, I.; Kim, J. Effects of larval extracts from identified Protaetia brevitarsis seulensis against benign prostatic hyperplasia induced by testosterone in rats. Food Sci. Nutr. 2021, 9, 5361–5369. [Google Scholar] [CrossRef]
- Lee, S.; Seo, Y.H.; Song, J.H.; Kim, W.J.; Lee, J.H.; Moon, B.C.; Ang, M.J.; Kim, S.H.; Moon, C.; Lee, J.; et al. Neuroprotective Effect of Protaetia brevitarsis seulensis’ Water Extract on Trimethyltin-Induced Seizures and Hippocampal Neurodegeneration. Int. J. Mol. Sci. 2021, 22, 679. [Google Scholar] [CrossRef]
- Lee, J.; Lee, W.; Kim, M.-A.; Hwang, J.S.; Na, M.; Bae, J.-S. Inhibition of platelet aggregation and thrombosis by indole alkaloids isolated from the edible insect Protaetia brevitarsis seulensis (Kolbe). J. Cell Mol. Med. 2017, 21, 1217–1227. [Google Scholar] [CrossRef]
- Yoo, Y.C.; Shin, B.-H.; Hong, J.-H.; Lee, J.; Chee, H.-Y.; Song, K.-S.; Lee, K.-B. Isolation of fatty acids with anticancer activity from Protaetia brevitarsis larva. Arch. Pharm. Res. 2007, 30, 361–365. [Google Scholar] [CrossRef]
- Nikkhah, A.; Van Haute, S.; Jovanovic, V.; Jung, H.; Dewulf, J.; Cirkovic Velickovic, T.; Ghnimi, S. Life cycle assessment of edible insects (Protaetia brevitarsis seulensis larvae) as a future protein and fat source. Sci. Rep. 2021, 11, 14030. [Google Scholar] [CrossRef]
- Lai, D.; Wang, Q.; Wu, Y.; Shu, C.; Zhang, Y.; Liu, C. Effect of Protaetia brevitarsis (Lewis) larvae larvae dung on development of pepper seedling stage under low temperature. North. Hortic. 2019, 8, 63–66. [Google Scholar]
- Pizzeghello, D.; Schiavon, M.; Francioso, O.; Vecchia, F.D.; Ertani, A.; Nardi, S. Bioactivity of Size-Fractionated and Unfractionated Humic Substances From Two Forest Soils and Comparative Effects on N and S Metabolism, Nutrition, and Root Anatomy of Allium sativum L. Front. Plant Sci. 2020, 11, 1203. [Google Scholar] [CrossRef] [PubMed]
- Jindo, K.; Olivares, F.L.; Malcher, D.J.D.P.; Sánchez-Monedero, M.A.; Kempenaar, C.; Canellas, L.P. From Lab to Field: Role of Humic Substances Under Open-Field and Greenhouse Conditions as Biostimulant and Biocontrol Agent. Front. Plant Sci. 2020, 11, 426. [Google Scholar] [CrossRef] [PubMed]
- Bredon, M.; Dittmer, J.; Noël, C.; Moumen, B.; Bouchon, D. Lignocellulose degradation at the holobiont level: Teamwork in a keystone soil invertebrate. Microbiome 2018, 6, 162. [Google Scholar] [CrossRef] [Green Version]
- Frouz, J. Effects of soil macro- and mesofauna on litter decomposition and soil organic matter stabilization. Geoderma 2018, 332, 161–172. [Google Scholar] [CrossRef]
- Zhao, X.; Shen, J.P.; Shu, C.L.; Jin, S.S.; Di, H.J.; Zhang, L.M.; He, J.Z. Attenuation of antibiotic resistance genes in livestock manure through vermicomposting via Protaetia brevitarsis and its fate in a soil-vegetable system. Sci. Total Environ. 2021, 807 Pt 1, 150781. [Google Scholar] [CrossRef]
- Lee, S.A.; Heo, J.; Kim, M.A.; Tamura, T.; Saitou, S.; Kwon, S.W.; Weon, H.Y. Protaetiibacter larvae sp. nov. and Agromyces intestinalis sp. nov., isolated from the gut of larvae of Protaetia brevitarsis seulensis, reclassification of Lysinimonas yzui as Pseudolysinimonas yzui comb. nov. and emended description of the genus Pseudolysinimonas. Int. J. Syst. Evol. Microbiol. 2021, 71, 004669. [Google Scholar]
- Maheswari, N.U.; Abirami, R. A review on: Effective microorganisms and it applications. Asian J. Multidimens. Res. (AJMR) 2019, 8, 121–129. [Google Scholar] [CrossRef]
- Reis, V.M.; Alves, B.J.R.; Hartmann, A.; James, E.K.; Zilli, J.E. Beneficial microorganisms in agriculture: The future of plant growth-promoting rhizobacteria. Plant Soil 2020, 451, 1–3. [Google Scholar] [CrossRef] [Green Version]
- Ma, Y. Seed coating with beneficial microorganisms for precision agriculture. Biotechnol. Adv. 2019, 37, 107423. [Google Scholar] [CrossRef]
- Mahawar, H.; Prasanna, R. Prospecting the interactions of nanoparticles with beneficial microorganisms for developing green technologies for agriculture. Environ. Nanotechnol. Monit. Manag. 2018, 10, 477–485. [Google Scholar] [CrossRef]
- Jacobsen, B.J.; Zidack, N.K.; Larson, B.J. The role of bacillus-based biological control agents in integrated pest management systems: Plant diseases. Phytopathology 2004, 94, 1272–1275. [Google Scholar] [CrossRef] [PubMed] [Green Version]
- Zhou, Q.; Li, K.; Jun, X.; Bo, L. Role and functions of beneficial microorganisms in sustainable aquaculture. Bioresour. Technol. 2009, 100, 3780–3786. [Google Scholar] [CrossRef] [PubMed]
- Wang, K.; Liu, Q.; Liu, C.; Geng, L.; Wang, G.; Zhang, J.; Shu, C. Dominant egg surface bacteria of Holotrichia oblita (Coleoptera: Scarabaeidae) inhibit the multiplication of Bacillus thuringiensis and Beauveria bassiana. Sci. Rep. 2021, 11, 9499. [Google Scholar] [CrossRef] [PubMed]
- Masella, A.P.; Bartram, A.K.; Truszkowski, J.M.; Brown, D.G.; Neufeld, J.D. PANDAseq: Paired-end assembler for illumina sequences. BMC Bioinform. 2012, 13, 31. [Google Scholar] [CrossRef] [PubMed] [Green Version]
- Edgar, R.C.; Haas, B.J.; Clemente, J.C.; Quince, C.; Knight, R. UCHIME improves sensitivity and speed of chimera detection. Bioinformatics 2011, 27, 2194–2200. [Google Scholar] [CrossRef] [PubMed] [Green Version]
- Edgar, R.C. UPARSE: Highly accurate OTU sequences from microbial amplicon reads. Nat. Methods 2013, 10, 996–998. [Google Scholar] [CrossRef] [PubMed]
- McDonald, D.; Price, M.N.; Goodrich, J.; Nawrocki, E.P.; DeSantis, T.Z.; Probst, A.; Andersen, G.L.; Knight, R.; Hugenholtz, P. An improved Greengenes taxonomy with explicit ranks for ecological and evolutionary analyses of bacteria and archaea. ISME J. 2012, 6, 610–618. [Google Scholar] [CrossRef]
- Bolger, A.M.; Lohse, M.; Usadel, B. Trimmomatic: A flexible trimmer for Illumina sequence data. Bioinformatics 2014, 30, 2114–2120. [Google Scholar] [CrossRef] [Green Version]
- Bankevich, A.; Nurk, S.; Antipov, D.; Gurevich, A.A.; Dvorkin, M.; Kulikov, A.S.; Lesin, V.M.; Nikolenko, S.I.; Pham, S.; Prjibelski, A.D.; et al. SPAdes: A new genome assembly algorithm and its applications to single-cell sequencing. J. Comput. Biol. 2012, 19, 455–477. [Google Scholar] [CrossRef] [Green Version]
- Besemer, J.; Borodovsky, M. GeneMark: Web software for gene finding in prokaryotes, eukaryotes and viruses. Nucleic Acids Res. 2005, 33, W451–W454. [Google Scholar] [CrossRef] [Green Version]
- Xu, Z.; Hao, B. CVTree update: A newly designed phylogenetic study platform using composition vectors and whole genomes. Nucleic Acids Res. 2009, 37, W174–W178. [Google Scholar] [CrossRef] [PubMed] [Green Version]
- Blin, K.; Shaw, S.; Steinke, K.; Villebro, R.; Ziemert, N.; Lee, S.Y.; Medema, M.H.; Weber, T. antiSMASH 5.0: Updates to the secondary metabolite genome mining pipeline. Nucleic Acids Res. 2019, 47, W81–w87. [Google Scholar] [CrossRef] [PubMed] [Green Version]
- Tian, S.; Liu, N.; Wang, G. Application of Confrontation Culture Method in the Study of Inhibitory Effect of Biocontrol Microorganisms. Henan Agric. Sci. 2019, 48, 1–6. [Google Scholar]
- David, J.F. The role of litter-feeding macroarthropods in decomposition processes: A reappraisal of common views. Soil Biol. Biochem. 2014, 76, 109–118. [Google Scholar] [CrossRef] [Green Version]
- Tegtmeier, D.; Hurka, S.; Mihajlovic, S.; Bodenschatz, M.; Schlimbach, S.; Vilcinskas, A. Culture-Independent and Culture-Dependent Characterization of the Black Soldier Fly Gut Microbiome Reveals a Large Proportion of Culturable Bacteria with Potential for Industrial Applications. Microorganisms 2021, 9, 1642. [Google Scholar] [CrossRef]
- Poveda, J.; González-Andrés, F. Bacillus as a source of phytohormones for use in agriculture. Appl. Microbiol. Biotechnol. 2021, 105, 8629–8645. [Google Scholar] [CrossRef]
- Santos, E.N.; Menezes, L.P.; Dolabella, S.S.; Santini, A.; Severino, P.; Capasso, R.; Zielinska, A.; Souto, E.B.; Jain, S. Bacillus thuringiensis: From biopesticides to anticancer agents. Biochimie 2021, 192, 83–90. [Google Scholar] [CrossRef]

| Sample | OTU | Chao1 | Shannon-2 | Simpson | ||||
|---|---|---|---|---|---|---|---|---|
| Average | SD | Average | SD | Average | SD | Average | SD | |
| SC9 | 1595.20 | 312.41 | 1927.32 | 465.45 | 7.26 | 0.22 | 0.0357 | 0.0147 |
| RS | 2736.50 | 223.67 | 3048.20 | 203.78 | 9.29 | 0.12 | 0.0058 | 0.0006 |
| F | 2665.60 | 246.70 | 3053.10 | 260.38 | 8.56 | 0.22 | 0.0093 | 0.0014 |
| LH | 2978.83 | 195.02 | 3296.92 | 158.72 | 8.93 | 0.31 | 0.0119 | 0.0045 |
| Isolate | Reads | Contigs | |||
|---|---|---|---|---|---|
| Accession No. | Clean Data (Gb) | Total Bases (Mb) | N50 Length (Mb) | CDs No. | |
| CFG2 | SRR16943721 | 1.83 | 4.96 | 0.23 | 3230 |
| CFG3 | SRR16943720 | 1.66 | 4.18 | 1.07 | 2948 |
| CFG6 | SRR16943709 | 0.98 | 4.24 | 0.36 | 3169 |
| CFG10 | SRR16943708 | 2.16 | 4.27 | 0.89 | 3010 |
| CFG11 | SRR16943707 | 0.98 | 4.19 | 0.36 | 3097 |
| CFG13 | SRR16943706 | 2.13 | 4.78 | 1.02 | 3780 |
| CFS2 | SRR16943705 | 1.07 | 4.26 | 0.50 | 3071 |
| CFS5 | SRR16943704 | 1.17 | 4.10 | 1.02 | 2876 |
| CFS6 | SRR16943703 | 1.98 | 4.92 | 0.37 | 3148 |
| CFS8 | SRR16943719 | 1.04 | 4.12 | 0.99 | 3050 |
| CFS15 | SRR16943718 | 1.04 | 4.06 | 1.02 | 2965 |
| PGCF23 | SRR16943713 | 1.02 | 4.16 | 0.62 | 2972 |
| YMCF3 | SRR16943711 | 0.98 | 4.07 | 1.02 | 2984 |
| Cluster | CFG2 | CFG3 | CFG6 | CFG10 | CFG11 | CFG13 | CFS2 | CFS5 | CFS6 | CFS8 | CFS15 | PGCF23 | YMCF3 |
|---|---|---|---|---|---|---|---|---|---|---|---|---|---|
| Bacilysin | 100 | 100 | 100 | 100 | 100 | 100 | 100 | 100 | 100 | 100 | 100 | 100 | 100 |
| Subtilosin A | 100 | 100 | 100 | 100 | 100 | 100 | 100 | 100 | 100 | 100 | 100 | 100 | |
| Bacillaene | 100 | 100 | 100 | 100 | 100 | 100 | 100 | 100 | 100 | 100 | 100 | 100 | 100 |
| Bacillibactin | 84 | 100 | 84 | 100 | 84 | 100 | 100 | 100 | 100 | 100 | 100 | 100 | 100 |
| Fengycin | 80 | 73 | 80 | 73 | 80 | 86 | 80 | 86 | 73 | 80 | 73 | 80 | |
| Subtilin | 100 | 100 | |||||||||||
| SKF | 100 | 100 | 100 | ||||||||||
| Difficidin | 100 | ||||||||||||
| Macrolactin H | 100 | ||||||||||||
| Mersacidin | 100 |
Publisher’s Note: MDPI stays neutral with regard to jurisdictional claims in published maps and institutional affiliations. |
© 2022 by the authors. Licensee MDPI, Basel, Switzerland. This article is an open access article distributed under the terms and conditions of the Creative Commons Attribution (CC BY) license (https://creativecommons.org/licenses/by/4.0/).
Share and Cite
Xuan, H.; Gao, P.; Du, B.; Geng, L.; Wang, K.; Huang, K.; Zhang, J.; Huang, T.; Shu, C. Characterization of Microorganisms from Protaetia brevitarsis Larva Frass. Microorganisms 2022, 10, 311. https://doi.org/10.3390/microorganisms10020311
Xuan H, Gao P, Du B, Geng L, Wang K, Huang K, Zhang J, Huang T, Shu C. Characterization of Microorganisms from Protaetia brevitarsis Larva Frass. Microorganisms. 2022; 10(2):311. https://doi.org/10.3390/microorganisms10020311
Chicago/Turabian StyleXuan, Huina, Peiwen Gao, Baohai Du, Lili Geng, Kui Wang, Kun Huang, Jie Zhang, Tianpei Huang, and Changlong Shu. 2022. "Characterization of Microorganisms from Protaetia brevitarsis Larva Frass" Microorganisms 10, no. 2: 311. https://doi.org/10.3390/microorganisms10020311
APA StyleXuan, H., Gao, P., Du, B., Geng, L., Wang, K., Huang, K., Zhang, J., Huang, T., & Shu, C. (2022). Characterization of Microorganisms from Protaetia brevitarsis Larva Frass. Microorganisms, 10(2), 311. https://doi.org/10.3390/microorganisms10020311

